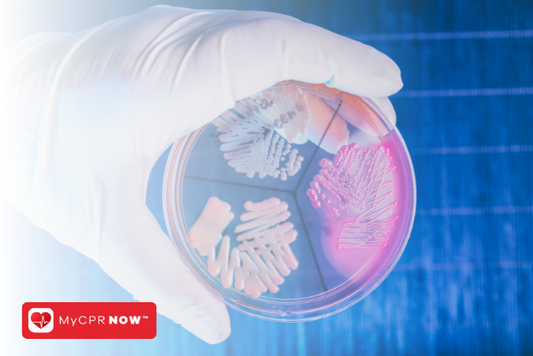
Bloodborne Pathogens: The Importance of Being Certified

MyCPR NOW Blog

CPR Certification: A Life-Changing Journey
Are you looking to become a certified lifeguard, but don't know where to start? Are you worried about the cost of classes and certification tests? Take heart! There are many...
Read MoreCPR Certification: A Life-Changing Journey
Are you looking to become a certified lifeguard, but don't know where to start? Are you worried about the cost of classes and certification tests? Take heart! There are many...

Unpacking the Importance of First Aid Certification
Introduction First aid is an essential skill for everyone to know. You can reduce the chances of injury in a variety of situations, keep yourself and others safe by knowing...
Read MoreUnpacking the Importance of First Aid Certification
Introduction First aid is an essential skill for everyone to know. You can reduce the chances of injury in a variety of situations, keep yourself and others safe by knowing...

How First Aid Certification Can Save Lives
In a world where people are constantly on the go, it's important to be prepared for anything. Being able to offer first aid in a crisis can mean the difference...
Read MoreHow First Aid Certification Can Save Lives
In a world where people are constantly on the go, it's important to be prepared for anything. Being able to offer first aid in a crisis can mean the difference...

The Role of First Aid Certification in Saving Lives
Introduction First aid certification is a valuable tool to have, even if you think you'll never be in a situation where it's needed. It can help save lives and make...
Read MoreThe Role of First Aid Certification in Saving Lives
Introduction First aid certification is a valuable tool to have, even if you think you'll never be in a situation where it's needed. It can help save lives and make...
Bloodborne Pathogens: The Importance of Being Certified
Bloodborne Pathogens With the setting of strict standards for workplace safety, it's more important than ever to hire qualified employees. A good way to prove your commitment to workplace safety...
Read MoreBloodborne Pathogens: The Importance of Being Certified
Bloodborne Pathogens With the setting of strict standards for workplace safety, it's more important than ever to hire qualified employees. A good way to prove your commitment to workplace safety...

Pet CPR: A Critical Skill for Every Pet Owner
The estimates that over half of all homes in the U.S. have at least one pet, and that number is on the rise. With so many different types of animals...
Read MorePet CPR: A Critical Skill for Every Pet Owner
The estimates that over half of all homes in the U.S. have at least one pet, and that number is on the rise. With so many different types of animals...
